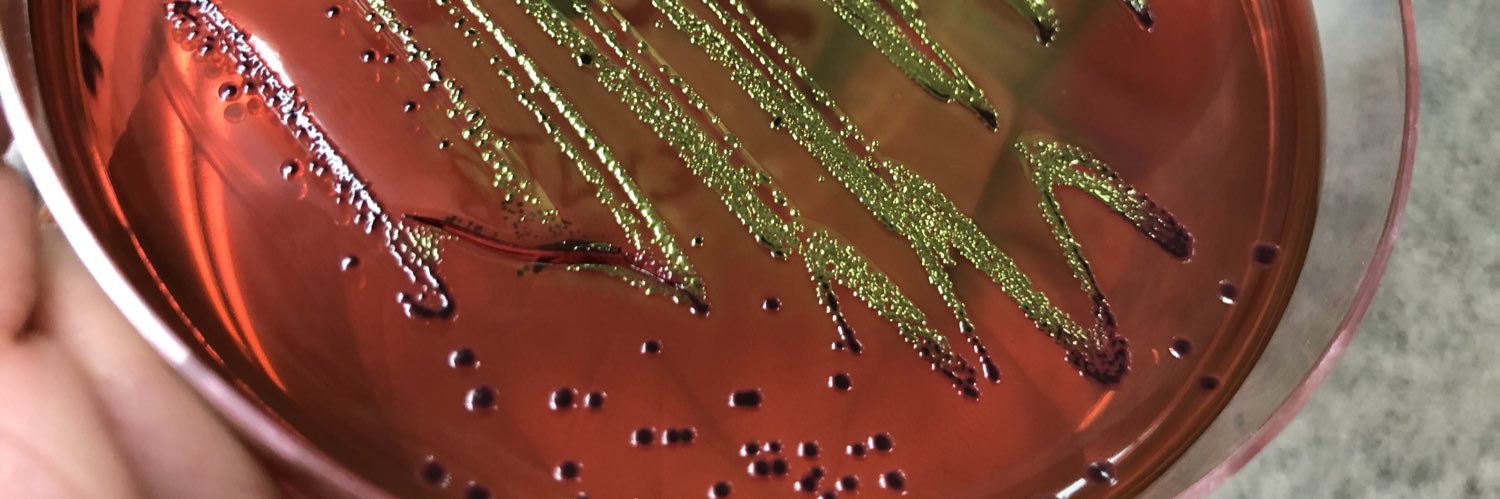
Eduardo Pérez Roth banner

Sabitlenmiş Tweet
Eduardo Pérez Roth retweetledi

Con la que está cayendo con #COVID2019, ahora más que nunca, queda clara la necesidad de que las asignaturas desaparecidas Virología e Inmunología vuelvan al Grado en Biología de la @ULL
Español
Eduardo Pérez Roth
1.2K posts

@eperroth
Lecturer in Microbiology, @ULL. Science, Microbes, Antimicrobial Resistance.









New empirical study challenges the claim that ChatGPT undermines critical thinking. When used in structured and engaged ways, interaction with ChatGPT is associated with improved critical reasoning rather than its displacement. Link: sciencedirect.com/science/articl…






For the first time, scientists can actually watch #bacteria "harpoon" DNA in the environment to speed up their evolution! Researchers at @IUBloomington report how they did it in today's @NatureMicrobiol. go.iu.edu/21C5





